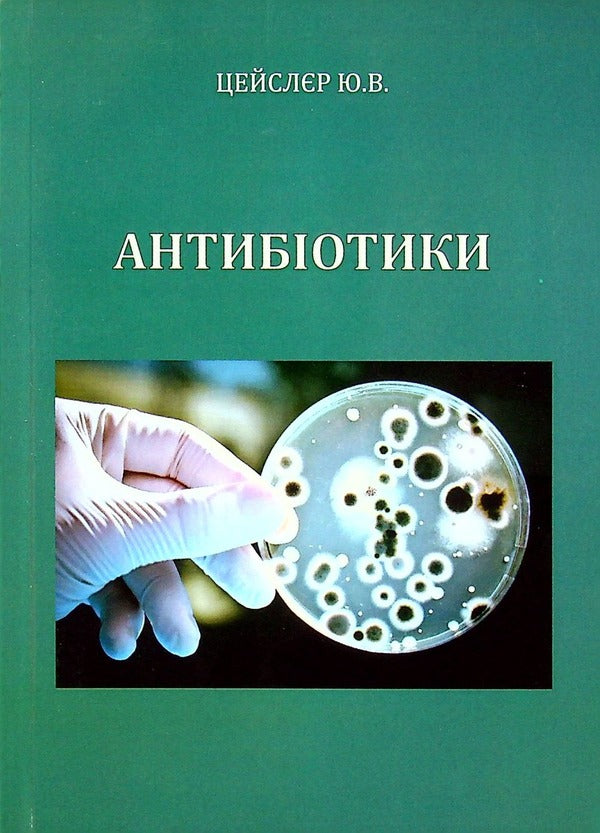
Antibiotics / Антибіотики Юлия Цейслер -1

1
/
of
6
Антибіотики. Antibiotics
Антибіотики. Antibiotics
Regular price
$40.00 USD
Regular price
$52.00 USD
Sale price
$40.00 USD
Taxes included.
Shipping calculated at checkout.
Quantity
Couldn't load pickup availability
Share
Author
Author
Julia Zeisler / Юлія Цейслер
Dimension
Dimension
145x200mm (5,7'x7,9')
ISBN
ISBN
Does not apply
Format
Format
Paperback
Language
Language
Ukrainian
Page Count
Page Count
186
Publisher
Publisher
Университет Украина
Year of book publication
Year of book publication
2013
Антибіотики. Antibiotics
У навчальному посібнику розглянуті основи знать про антибіотики.
SPECIFICATIONS:
Author:Julia Zeisler - Юлія Цейслер
Publisher:Университет Украина
Language:Ukrainian/Українська
Publication Date:2013
Number of pages:186 pst
Format:Paperback
Width:145 mm / 5,7'
Height:200 mm / 7,9'
Weight:210 g
ISBN:Does not apply